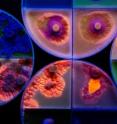
Researchers found that the fungus that causes white-nose syndrome in bats (shown here under UV light) can survive under a variety of conditions and can live and grow on most carbon and nitrogen sources in caves.

Fungus that causes white-nose syndrome in bats proves hardy survivor
After taking an in-depth look at the basic biology of a fungus that is decimating bat colonies as it spreads across the U.S., researchers report that they can find little that might stop the organism from spreading further and persisting indefinitely in bat caves. Their report appears in the journal PLOS ONE.
The aptly named fungus Pseudogymnoascus (Geomyces) destructans causes white-nose syndrome in bats. The infection strikes bats during their winter hibernation, leaving them weakened and susceptible to starvation and secondary infections. The fungus, believed to have originated in Europe, was first seen in New York in the winter of 2006-2007, and now afflicts bats in more than two dozen states. According to the U.S. Fish and Wildlife Service, P. destructans has killed more than 5.5 million bats in the U.S. and Canada.
The fungus thrives at low temperatures, and spreads to bats whose body temperature drops below 20 degrees Celsius (68 degrees Fahrenheit) when they are hibernating in infected caves. Previous research has shown that the fungus persists in caves even after the bats are gone.
The new study, from researchers at the Illinois Natural History Survey at the University of Illinois, found that the fungus can make a meal out of just about any carbon source likely to be found in caves, said graduate student Daniel Raudabaugh, who led the research under the direction of survey mycologist Andrew Miller.
"It can basically live on any complex carbon source, which encompasses insects, undigested insect parts in guano, wood, dead fungi and cave fish," Raudabaugh said. "We looked at all the different nitrogen sources and found that basically it can grow on all of them. It can grow over a very wide range of pH; it doesn't have trouble in any pH unless it's extremely acidic."
"P. destructans appears to create an environment that should degrade the structure of keratin, the main protein in skin," Raudabaugh said. It has enzymes that break down urea and proteins that produce a highly alkaline environment that could burn the skin, he said. Infected bats often have holes in their skin, which can increase their susceptibility to other infections.
The fungus can subsist on other proteins and lipids on the bats' skin, as well as glandular secretions, the researchers said.
"P. destructans can tolerate naturally occurring inhibitory sulfur compounds, and elevated levels of calcium have no effect on fungal growth," Raudabaugh said.
The only significant limitation of the fungus besides temperatures above 20 degrees Celsius has to do with its ability to take up water, Raudabaugh said. Its cells are leaky, making it hard for the fungus to absorb water from surfaces, such as dry wood, that have a tendency to cling to moisture. But in the presence of degraded fats or free fatty acids, like those found on the skin of living or dead animals, the fungus can draw up water more easily, he said.
"All in all the news for hibernating bats in the U.S. is pretty grim," Miller said.
"When the fungus first showed up here in Illinois earlier this year we went from zero to 80 percent coverage in a little more than a month," he said. The team led by U. of I. researchers that discovered the fungus in the state found a single infected bat in one northern Illinois cave, he said. Several weeks later most of the bats in that cave were infected.
Although many studies have been done on the fungal genome and on the bats, Miller said, Raudabaugh is the first to take an in-depth look at the basic biology of the fungus.
"Dan found that P. destructans can live perfectly happily off the remains of most organisms that co-inhabit the caves with the bats," Miller said. "This means that whether the bats are there or not, it's going to be in the caves for a very long time."
The Illinois Natural History Survey is a division of the Prairie Research Institute at the U. of I.
This study was funded through awards given by the Illinois Department of Natural Resources State Wildlife Grants Program (project number T-78-R-1) and the Section 6 Endangered and Threatened Species Program (project number E-54-R-1) to the Illinois Natural History Survey.
Source: University of Illinois at Urbana-Champaign
Other sources
- Fungus that causes white-nose syndrome in bats proves hardy survivorfrom Science DailyFri, 25 Oct 2013, 14:00:39 UTC
- Fungus that causes white-nose syndrome in bats proves hardy survivorfrom PhysorgFri, 25 Oct 2013, 12:30:38 UTC